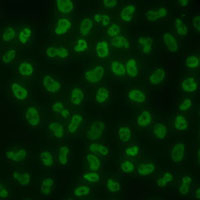

产品描述:Rabbit polyclonal antibody to SLM2免疫原:Recombinant full length protein of human SLM2纯化方式:The antibody was purified by immunogen affinity chromatography.克隆类型:Polyclonal产品形式:Liquid in 0.42% Potassium phosphate, 0.87% Sodium chloride, pH 7.3, 30% glycerol, and 0.01% sodium azide.稀释比:WB (1/500 - 1/2000), IF/IC (1/50 - 1/200)基因名称:KHDRBS3相关名称:SALP; SLM2; KH domain-containing, RNA-binding, signal transduction-associated protein 3; RNA-binding protein T-Star; Sam68-like mammalian protein 2; SLM-2; Sam68-like phosphotyrosine protein
基因编号(人):
10656;
基因编号(小鼠):
13992;
蛋白编号(人):
O75525;
蛋白编号(小鼠):
Q9R226;
储存效期:Shipped at 4°C. Upon delivery aliquot and store at -20°C for one year. Avoid freeze/thaw cycles.
-
 Western blot analysis of SLM2 expression in HepG2 (A), Jurkat (B) whole cell lysates. (Predicted band size: 38 kD; Observed band size: 38 kD)
Western blot analysis of SLM2 expression in HepG2 (A), Jurkat (B) whole cell lysates. (Predicted band size: 38 kD; Observed band size: 38 kD) -
Immunofluorescent analysis of SLM2 staining in MCF7 cells . Formalin-fixed cells were permeabilized with 0.1% Triton X-100 in TBS for 5-10 minutes and blocked with 3% BSA-PBS for 30 minutes at room temperature. Cells were probed with the primary antibody in 3% BSA-PBS and incubated overnight at 4 °C in a humidified chamber. Cells were washed with PBST and incubated with a AF488-conjugated secondary antibody (green) in PBS at room temperature in the dark. DAPI was used to stain the cell nuclei (blue).
Immunofluorescent analysis of SLM2 staining in MCF7 cells . Formalin-fixed cells were permeabilized with 0.1% Triton X-100 in TBS for 5-10 minutes and blocked with 3% BSA-PBS for 30 minutes at room temperature. Cells were probed with the primary antibody in 3% BSA-PBS and incubated overnight at 4 °C in a humidified chamber. Cells were washed with PBST and incubated with a AF488-conjugated secondary antibody (green) in PBS at room temperature in the dark. DAPI was used to stain the cell nuclei (blue).


 说明书
说明书 MSDS
MSDS